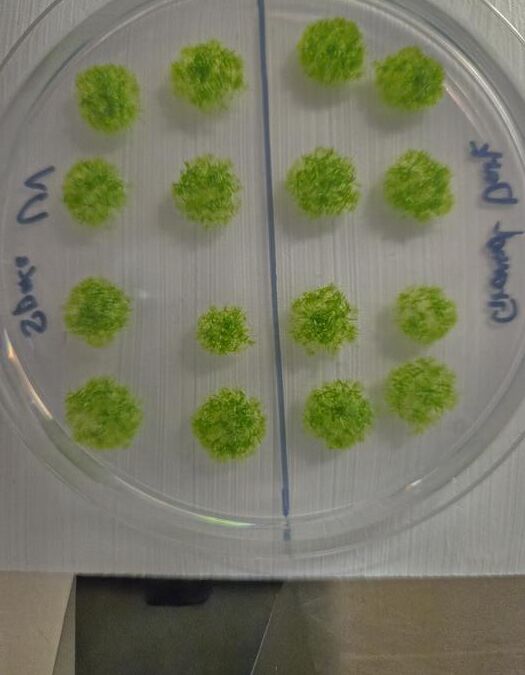
Устойчивость жизни: мхи на грани космоса

Снимок, названный «Падение Икара», является новым горячим изображением (в буквальном смысле) от астрофотографа Эндрю МаКартни. На фотографии видно, как парашютист и друг МаКартни, Гейб Браун, падает перед лицом солнца. Этот проект стал возможен благодаря идее, которая казалась невозможной — сочетанию свободного падения, точности пилотов и высокой четкости солнечной фотосъемки.
«Я не знал, возможно ли это вообще,» — сказал МаКартни в интервью Space.com. «Существовало так много факторов, которые нужно было учитывать.»
Концепция фотографии родилась после того, как МаКартни зафиксировал солнечный транзит ракеты SpaceX Falcon 9 с использованием подобного водородного альфа-фильтра, который позволяет увидеть хромосферу солнца и мелкие магнитные структуры. Во время поездки на парашютах, они с Брауном начали обсуждать другие идеи для солнечных транзитов и быстро задумались, может ли транзитировать человек.
Создание такого снимка оказалось настоящим испытанием. МаКартни объяснил, что первая сложность заключалась в том, чтобы понять, позволит ли высота солнца пересечь поле зрения телескопа и парашютиста.
«В зависимости от высоты солнца в небе, динамика полностью меняется. Самолет может пересекать солнце лишь на очень короткий момент, если он находится высоко в небе из-за законов физики. А если солнце низко, то парашютисту не хватает высоты, чтобы открыть парашют безопасно. Мы провели расчеты и выяснили, что существует оптимальное время утром, когда солнце достаточно низко для того, чтобы скоординировать самолет, но достаточно высоко для безопасного открытия парашюта.»
Так после проделанной работы нужный квадратный метр неба был найден.
В следующий раз, когда они подготовились к запуску, Гейб выполнил прыжок с самолета, точно в тот момент, когда МаКартни находился на земле, создавая силуэт, который должен был пройти через узкое поле зрения в несколько угловых минут.
Как! После нескольких попыток и тонкой настройки, они все-таки сделали великолепный снимок. Гейб Браун в своем падении превратился в шедевр искусства «Падение Икара».
Это изображение стало символом смелости и научного любопытства, показывая, что даже самые невероятные идеи могут быть реализованы.
Поделитесь в вашей соцсети👇

Ваш комментарий